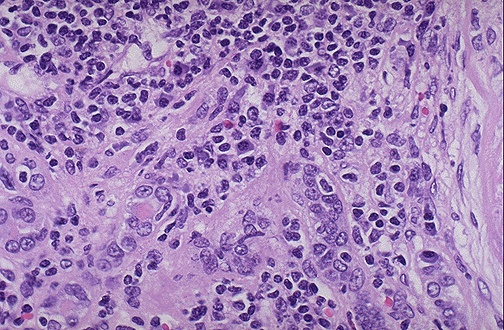

| Both lymphocytes and plasma cells are seen in this case of chronic pyelonephritis. It is not uncommon to see lymphocytes accompany just about any chronic renal disease: glomerulonephritis, nephrosclerosis, pyelonephritis. However, the plasma cells are most characteristic for chronic pyelonephritis. |
![]() |